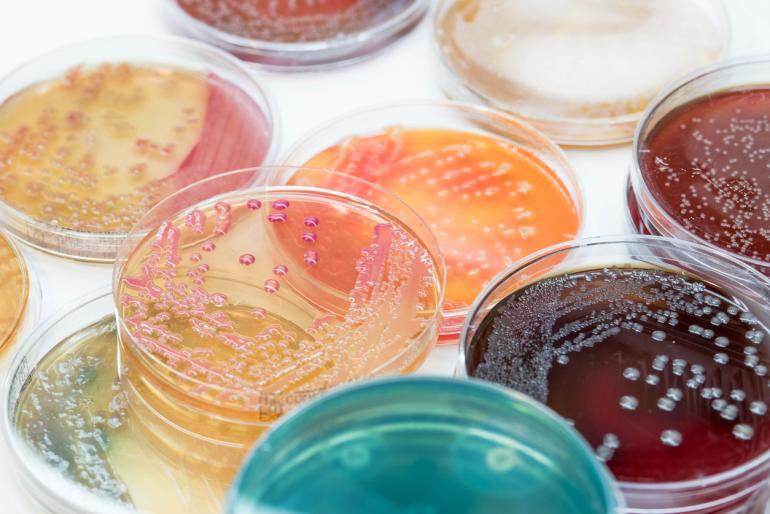

Železo podporuje bakteriální infekce
Z celého nesmírného propletence bakteriálních interakcí dnes vidíme jen onu příslovečnou špičku ledovce. V roce 1952 viděla lékařská věda pouze špičku té špičky. Weinberg věděl, jak málo toho tehdejší věda zná, a věděl také, jak nepředvídatelné mohou bakterie být, i rozhodl se otestovat, jak budou antibiotika reagovat na přítomnost či nepřítomnost určitých chemických prvků ve stravě jeho ženy.
Ve své laboratoři na Indiánské univerzitě přikázal své asistentce naplnit desítky Petriho misek třemi pokusnými složkami - tetracyklinem, bakteriemi a dále organickou či minerální živinou, která se lišila misku od misky. Několik dní nato se v jedné z misek bakterie rozmnožily natolik, že si Weinbergova asistentka pomyslela, že do ní zapomněla přidat antibiotika. Test s danou živinou tedy opakovala, dočkala se však stejného výsledku - masivního bakteriálního růstu. Živina v daném vzorku dodávala bakteriím tolik "paliva", že účinky antibiotika zcela potlačila. Ano, uhádli jste, bylo to železo.
Weinberg dále dokázal, že dostatečný přísun železa umožňuje téměř všem bakteriím prakticky neomezený růst. Od toho okamžiku zasvětil svůj život snaze porozumět negativním účinkům nadměrné konzumace železa na lidský organismus a vlivu železa na ostatní formy života.
Regulace železa v lidském těle je složitý proces, který zahrnuje prakticky všechny části těla. Zdravý dospělý jedinec je majitelem zhruba tří až čtyř gramů železa. Většina je obsažena v hemoglobinu a prostřednictvím krevního oběhu distribuuje kyslík, ale nejrůznější úložiště se nacházejí po celém těle. Vzhledem k tomu, že železo není jen životně důležitým prvkem, ale může být i smrtelně nebezpečnou přítěží, nemělo by nás překvapovat, že proti němu máme i obranné mechanismy.
Nejslabšími místy protiinfekčního obranného mechanismu jsou ta, kterými infekce vstupují do našeho těla. U dospělého jedince bez otevřených ran či porušené kůže jsou to ústa, oči, nos, uši a genitálie. A protože původci infekcí potřebují ke svému životu železo, prohlásil náš imunitní systém všechny tyto otvory za železné bezletové zóny a jako stráž k nim postavil tzv. chelátory, tedy bílkoviny, které blokují molekuly železa a brání jejich zneužívání. Vše od slz přes sliny po hleny se chelátory jen hemží.
To ale není vše, co náš protiželezný obranný systém umí. Když člověka složí nějaká nemoc, přepne jeho imunitní systém na nejvyšší výkon a spustí takzvanou reakci akutní fáze. Do krevního oběhu uvolní obranné proteiny, a zároveň uzamkne železo, aby jej biologičtí vetřelci nemohli použít proti nám. Je to vlastně jakýsi biologický ekvivalent vězeňského poplachu - poslat do chodeb hlídače a zabezpečit zbraně.
Zdá se, že k podobné reakci dochází, když se naše zdravé buňky změní v rakovinné a začnou se nekontrolované šířit. K tomu však potřebují železo, a tak se tělo snaží omezit jeho dostupnost. Nový farmaceutický výzkum prověřuje způsoby, jak tuto reakci prostřednictvím léků napodobit.
S tím, jak roste naše povědomí o závislosti bakterií na železe, si ztracenou úctu získávají i některé metody lidového léčitelství. Lidé si kdysi přikrývali zranění slámou namočenou do vaječných bílků, aby se ochránili před infekcí. Ukazuje se, že to nebylo vůbec hloupé - vaječné bílky jsou tu přece od toho, aby bojovaly s infekcemi. Vaječná skořápka je pórovitá, aby mohlo kuřecí embryo uvnitř "dýchat". Leč s pórovitou skořápkou je ta potíž, že nepropouští pouze vzduch, ale také nejrůznější nesympatické mikroby. A vaječný bílek slouží právě k tomu, aby tyto vetřelce zastavil. Bílky jsou doslova přecpané chelátory (proteiny, které na vstupních bodech těla blokují železo), jako je například ovofe-rin, které kuřecí embryo - tedy žloutek - chrání před infekcí.
Vztah mezi železem a infekcí je rovněž jednou z odpovědí na otázku, proč je kojení tak důležité z hlediska ochrany novorozenců před infekcí. Mateřské mléko totiž obsahuje laktoferin, chelátový protein, který váže železo, a tím brání bakteriálnímu růstu.
V minulosti při morových epidemiích byli zdraví dospělí muži nejohroženějším segmentem obyvatelstva, neboť děti a starší lidé tpěli obvykle podvýživou, a tím i nízkým obsahem železa v krvi, a dospělé ženy se pravidelně zbavovaly železa díky menstruaci, těhotenství a kojení. Hřebíček na hlavičku možná uhoidl Stephen Ell, profesor na Iowské univerzitě, který napsal: " Mortalita byla přímo úměrná obsahu železa v těle."
Nyní tedy víte, že i pro železo, stejně jako pro všechny dobré věci pod sluncem, platí rčení "všeho s mírou". To si však soudobá medicína nechtěla až do nedávná připustit. Železo je přece dobré, takže čím více železa, tím lépe.
Jistý lékař jménem John Murray pracoval se svou ženou v somálském uprchlickém táboře, když si povšiml, že spousta příslušníků nomádských kmenů, navzdory všudypřítomné anémii a opakovanému kontaktu s nejrůznějšími virulentními patogeny, jako je malárie, tuberkulóza či brucelóza, nejeví žádné viditelné známky infekce. Rozhodl se, že si na tuto anomálii posvítí. Nejprve začal léčit pouze část populace pomocí železa. Jakmile však v rámci boje proti anémii nasadil některým nomádům potravinové doplňky bohaté na železo, výskyt infekcí u těchto pacientů prudce stoupl. Somálští nomádi neoddávali těmto chorobám navzdory anémii, nýbrž díky ní. Proces blokace železa v nich běžel na plné obrátky.
Před pětatřiceti lety lékaři na Novém Zélandu pravidelně "očkovali" maorské děti železem. Předpokládali, že Maorové (původní obyvatelé Nového Zélandu) mají jídelníček chudý na železo a že jejich děti by proto trpěly anémii.
Pravděpodobnost onemocnění některou potenciálně smrtící chorobou, jako je otrava krve nebo meningitida, se v důsledku této praktiky u těchto dětí zvýšila až sedminásobně. Děti, stejně jako my všichni, si nosí v těle izolované kmeny potenciálně nebezpečných bakterií, které ovšem jejich imunitní systém drží na uzdě. Jakmile však lékaři nadopovali maorské děti železem, poskytli těmto bakteriím bohatou hostinu, samozřejmě s neblahými následky.
Infekční bujení však nemusí mít na svědomí pouze železo, které člověku vpraví do těla lékař injekcí. Palivem pro bakterie se mohou stát i železem obohacené potraviny. Ve střevech novorozenců se mohou vyskytovat spory botulismu (obsahuje je například med, což je jeden z důvodů, proč by rodiče neměli dávat dětem med, zejména před dosažením jednoho roku), které, pokud germinují, mohou mít smrtelné následky. Studie šedesáti devíti případů botulismu u kojenců v Kalifornii odhalila jeden zásadní rozdíl mezi smrtí a přežitím těchto dětí. Ty, které jejich matky namísto kojení krmily dětskou výživou obohacenou železem, byly mnohem mladší, když u nich nemoc propukla, a tím i zranitelnější. Z deseti dětí, které na botulismus zemřely, jich vyrůstalo na dětské výživě se zvýšeným obsahem železa deset.
Zdroj: Sharon Moalem - Zdraví zabíjí, Proč potřebujeme nemoci, nakladatelství Dokořán
Komentáře
- Pro vkládání komentářů se musíte registrovat nebo přihlásit
....ale spis jde o to neuzivat pri infekcich zelezo v potravinovych doplncich
- Pro vkládání komentářů se musíte registrovat nebo přihlásit
- Pro vkládání komentářů se musíte registrovat nebo přihlásit
- Pro vkládání komentářů se musíte registrovat nebo přihlásit

- Pro vkládání komentářů se musíte registrovat nebo přihlásit
Pošli odkaz